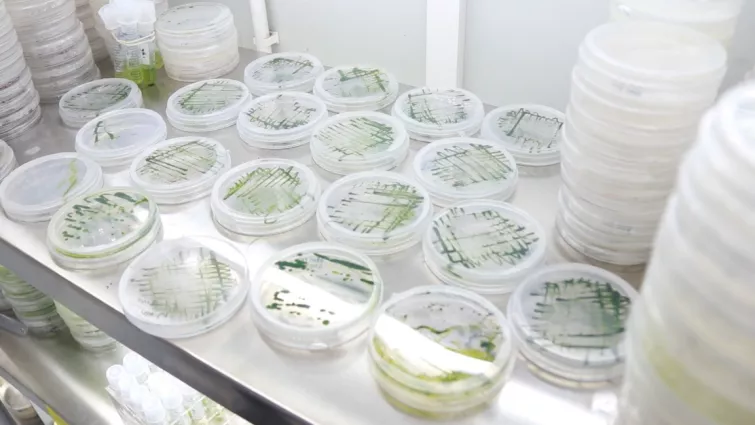

转载:https://mp.weixin.qq.com/s/U6VLC38p_f5hHRGrzMbcmA

如今,粤港澳大湾区的建设日新月异。大湾区,大机遇,大未来。越来越多的高端人才齐聚湾区城市,这其中就包括深圳欧美同学会常务副会长、现任深圳大学高等研究院院长、微藻研究领域的先行者——陈峰。
生于广东,留学澳洲,先后在香港、北京工作,他最终选择回到深圳,正是看中了粤港澳大湾区的光明前景及深圳“双区”驱动、“双区”叠加的黄金发展期。“深圳是粤港澳大湾区的核心城市之一,为海归提供了好的发展机会。我们希望能够搭乘深圳这趟快车,支持深圳的发展,并用科技成果回应伟大时代的召唤。”

陈峰在深圳大学高等研究院实验室内查看微藻情况。
勇攀科技高峰 持续深耕微藻研究
“微藻是一种无处不在的生物,它细胞里有很多高附加值的营养成分,可以作为能源、化工或者医药的原料。”在美丽的深圳大学校园内,陈峰谈起微藻如数家珍。
自从1987年开始接触微藻起,陈峰已在该领域深耕三十余年,早已名扬全球微藻界。尤其是他在国际上率先提出利用异养方式规模化高密度培养微藻,以生产高附加值功能性食品成分及藻类生物能源,深刻影响了微藻的规模化生产。还未从澳洲毕业,他已被香港大学聘请,随后又在2011年北上,任职北京大学工学院副院长。
2018年,粤港澳大湾区规划呼之欲出,向各方人才发出“邀请函”。在陈峰看来,地处大湾区的深圳有更大的发展空间,更好的平台做研究,自己也能利用现有的学术积累助力深圳和大湾区建设。于是他应深圳大学校长李清泉邀请,来深筹建高等研究院,“深圳浓厚的科研氛围,是我们科研工作者孜孜以求的。”

来到深圳后,陈峰牵头创立了微生物等重点实验室。
来到深圳大学后,陈峰继续勇攀科技高峰,先后创建了“深圳市海洋微生物组工程重点实验室”“深圳大学食品产业创新发展研究院”,并承担了国家重点研发计划和广东省珠江人才计划项目在内的5000 多万元的科研专项。另一方面,他也引入海外和北京大学的先进管理制度,为深圳科研和人才培养提供了更好的环境保障。
政府对于科研的重视和支持,让他印象十分深刻。同时他也表示,正是由于这种支持,深圳的科研环境不断优化,吸引了越来越多的科研人员来深发展,“2018年我刚来的时候,(深圳大学)高等研究院只有17位首席科学家,现在我们有四十多位,还有很多特聘教授。”
推动科研成果转化落地 为大湾区科技发展添砖加瓦
知识要转化为生产力,转化为真正的产品,服务社会需求,才是研究的真正意义。于是陈峰一边做科研,一边努力推动科研成果转化和落地应用。

陈峰与科研团队探讨微藻相关研究。
20世纪90年代末,微藻DHA出现,其所得产品品质远优于传统的鱼油DHA。但由于当时该技术被美国马泰克公司垄断,进口到中国的微藻DHA油每吨售价约170万元。2000年,陈峰将微藻研究成果应用于生产,带领国内某企业打破美国的技术垄断,实现微藻DHA在中国的产业化,使得微藻DHA油的价格下降至每吨30万元。目前,该企业微藻DHA生产线年产可达1000吨,已成为全球第二个利用微藻规模化生产高纯度DHA藻油的公司。
陈峰表示,微藻在生物能源领域也有一定的研发空间。
目前,国家正在大力推进碳中和、碳达峰工作。陈峰表示,微藻是生物能源研发领域的热门方向之一,未来希望通过带领深圳团队进行相关研究服务这一重大战略,服务大湾区建设。
